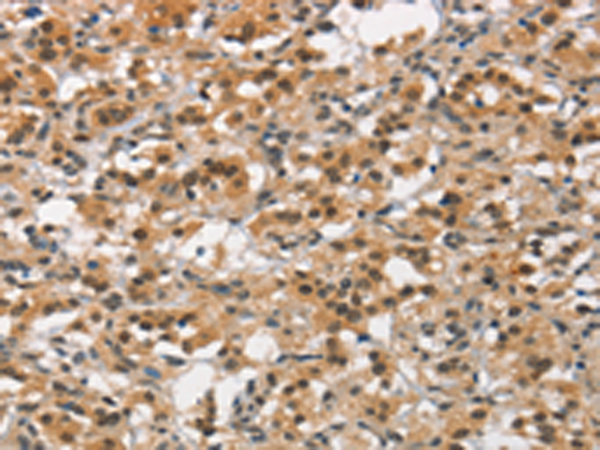

中文名稱:兔抗ANAPC4多克隆抗體
英文名稱: Anti-ANAPC4 rabbit polyclonal antibody
別 名: APC4
相關類別: 一抗
儲 存: 冷凍(-20℃)
宿 主: Rabbit
抗 原: ANAPC4
反應種屬: Human, Mouse
標 記 物: Unconjugate
克隆類型: rabbit polyclonal
技術規(guī)格
|
Background: |
A large protein complex, termed the anaphase-promoting complex (APC), or the cyclosome, promotes metaphase-anaphase transition by ubiquitinating its specific substrates such as mitotic cyclins and anaphase inhibitor, which are subsequently degraded by the 26S proteasome. Biochemical studies have shown that the vertebrate APC contains eight subunits. The composition of the APC is highly conserved in organisms from yeast to humans. The exact function of this gene product is not known. Two transcript variants encoding different isoforms have been found for this gene. |
|
Applications: |
ELISA, IHC |
|
Name of antibody: |
ANAPC4 |
|
Immunogen: |
Synthetic peptide of human ANAPC4 |
|
Full name: |
anaphase promoting complex subunit 4 |
|
Synonyms: |
APC4 |
|
SwissProt: |
Q9UJX5 |
|
ELISA Recommended dilution: |
2000-5000 |
|
IHC positive control: |
Human thyroid cancer and Human gastric cancer |
|
IHC Recommend dilution: |
25-100 |
購物車
購物車 幫助
幫助
 021-54845833/15800441009
021-54845833/15800441009
